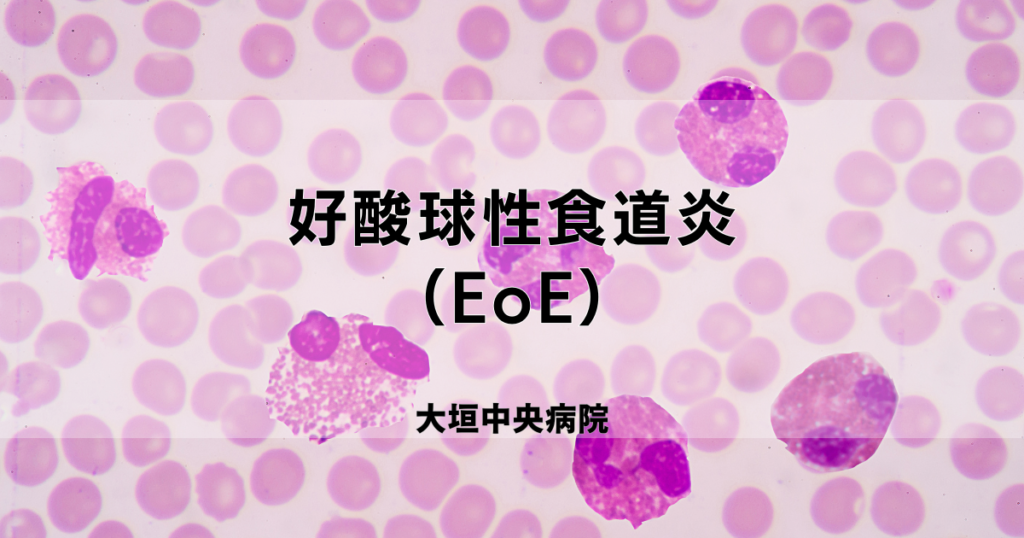
好酸球性食道炎の治療法は何ですか?

好酸球性食道炎 (EoE) は、食物が喉から胃まで移動する管である食道に影響を及ぼす疾患です。 EoEでは、好酸球と呼ばれる白血球が食道に蓄積します。好酸球は通常、食道には存在しません。
この好酸球の蓄積により炎症が引き起こされます。食道が狭くなり、飲み込むことが困難になることがあります。場合によっては、食べ物が食道に詰まることがあります。 EoE は痛みや胸やけの症状を引き起こすこともあります。
EoE がなぜ発生するのかは正確には不明です。好酸球の蓄積は、アレルギー反応によって引き起こされる可能性があります。典型的なアレルギーとは異なり、EoE のアレルギー反応は遅れます。これにより、どの食品が EoE の原因となっているのかを特定することが困難になる可能性があります。
EoE にはいくつかの治療選択肢があります。薬物療法は免疫反応を抑えて炎症を抑えるのに役立ちます。また、原因となる食品を排除する食事の変更も効果的です。
好酸球性食道炎の治療法は何ですか?
EoE の主な治療オプションは、投薬と食事の変更です。
EoE に使用される薬剤には次のものがあります。
- プロトンポンプ阻害剤 (PPI):一部の人々にとって、これらは EoE の一部である胸焼け症状の管理に役立ちます。
- ステロイド:これらの薬は食道の炎症を抑え、飲み込みやすくします。
- 生物学的製剤:デュピルマブ (Dupixent) は、EoE 用に承認された新しい生物学的製剤です。食道の炎症を引き起こす特定の免疫タンパク質を標的とします。
EoE のその他の治療法には次のものがあります。
- 除去食:除去食中は、最も一般的な食物アレルゲンの一部またはすべてを避けます。これは、EoE の症状を軽減するのに役立ちます。また、アレルギー反応を引き起こしている食品を特定する方法でもあります。
- エレメンタルダイエット:除去食で症状が解決しない場合は、エレメンタルダイエットが選択肢になる可能性があります。要素食では、食事からすべての固形食品を取り除きます。栄養は、飲んだり、栄養チューブから受け取ったりするアミノ酸配合物から摂取します。
- 食道拡張術:これは食道を伸ばして広げる処置で、再び飲み込みやすくします。嚥下が非常に難しい場合、または食道に食べ物が詰まっている場合には、医師がこの処置を行います。

好酸球性食道炎の最も効果的な治療法は何ですか?
PPI は多くの場合、EoE の第一選択治療です。それらは胃内の酸の生成を減らし、食道の炎症を軽減するのに役立つ可能性があります。
すべての人の EoE 症状が PPI に反応するわけではありません。その場合は、ステロイドや生物学的製剤などの他の治療法が処方されることがあります。
EoEの治療には、ステロイドまたは新しい生物学的製剤であるデュピルマブがよく使用されます。これらは食道の炎症を軽減するのに役立ち、食べ物が食道に詰まるリスクを軽減します。
フルチカゾンやブデソニドなどの EoE 用ステロイドは、食道の内層に接触するように飲み込まれます。しかしステロイドは誰にでも効くわけではありません。約
デュピルマブは週に一度の注射で投与されますが、その作用はステロイドとは少し異なります。食道の炎症を引き起こす特定の免疫タンパク質をブロックします。ステロイドは全体的な免疫反応を低下させます。
デュピルマブは、特に EoE の治療に承認された最初の薬剤です。他の生物学的製剤も EoE の治療に有望です。
EoE の治療に使用されるもう 1 つのアプローチは、食事の変更です。除去食は症状を緩和し、予防する効果的な方法です。最も一般的な除去食は、EoE におけるアレルギー反応に最も一般的に関連する食品を除去する 6 つの食品除去食です。 6 つの食品を除去するダイエット中は、次のことを避けます。
- 牛乳
- 小麦
- 卵
- ナッツ
- 大豆
- 魚介類
6 品目の食品除去食は、EoE 患者の約 73% に効果的であることが示されています。
他のタイプの除去食は、最も一般的なアレルゲンの一部を除去するだけです。制限はそれほど厳しくありませんが、多くの場合、それほど効果的ではありません。
要素食は EoE の治療に非常に効果的であることが示されています。
除去食または要素食を行った後は、徐々に食品を再開します。これは、EoE の症状を引き起こしているアレルギーのある特定の食品を特定するのに役立ちます。

好酸球性食道炎の新しい治療法は何ですか?
2022 年 5 月に、FDA は
デュピルマブは、食道に炎症を引き起こす特定の免疫タンパク質を標的とします。これらのタンパク質がブロックされると、症状が軽減されます。
臨床試験では、デュピルマブを毎週12週間注射した後、
EoEを治療するために現在試験中の他の生物学的薬剤もあります。これらの多くは、

食事は好酸球性食道炎を助けることができますか?
多くの場合、食事を変えると炎症が軽減され、EoE 症状が軽減されます。
EoE の症状は、食物アレルギーによって引き起こされることがよくあります。ただし、EoE は他の食物アレルギーとは異なります。通常、アレルギーのある食品を食べた直後に兆候や症状が現れます。しかし、EoEではアレルギー反応が遅れます。これにより、どの食品がアレルギー反応を引き起こしているのかを特定することがさらに複雑になる可能性があります。
どの食品が EoE 症状を引き起こしているのかを確実に知る唯一の方法は、除去食を行うことです。皮膚プリックテスト
排泄期間が終了したら、内視鏡検査を受けます。内視鏡検査では、医師がカメラを備えた長くて柔軟なチューブを挿入して、食道の炎症や、腫れ、白い斑点、水平方向のリングなどの EoE のその他の潜在的な兆候がないか検査します。医師は食道の好酸球レベルをチェックするために生検を行うこともあります。
別の種類の除去食は、4 つの食品除去食です。このダイエットでは次のことを避けてください。
- 牛乳
- 小麦
- 卵
- 大豆
この食事療法は、6 つの食品を除去する食事法よりも続けやすいですが、成功率は低くなります。 EoE患者の約41%から60%は、4品除去食で寛解を達成します。
EoEが寛解したら、食物を徐々に再導入できます。このプロセス全体を通じて、症状を監視します。炎症を調べるために定期的に内視鏡検査を受けることになるでしょう。
研究によると、EoE 患者の最大 31% には複数の食物誘因があることが示唆されています。牛乳と小麦はEoEの最も一般的な引き金となるため、最後に再導入する必要があります。
要素食は、EoE に使用される最も制限的な食事アプローチです。これには、食事からすべての食品を除去し、少なくとも 6 週間アミノ酸ミルクだけを飲むことが含まれます。場合によっては、代わりに栄養チューブを使用する必要があるかもしれません。
この食事療法は非常に効果的で、寛解率は約90%です。しかし、ミルクの味や値段、食事の制限などの理由から、続けるのが難しい場合もあります。要素食は通常、EoE が他の治療法に反応しなかった人々に対する一時的または救済療法として推奨されます。
持ち帰り
好酸球性食道炎(EoE)は、好酸球と呼ばれる白血球が食道に蓄積する状態です。これにより、炎症、痛み、嚥下困難が生じる可能性があります。多くの場合、食物に対するアレルギー反応によって引き起こされます。
EoE の治療には、ステロイドや生物学的製剤が含まれます。これらは両方とも免疫反応を低下させ、炎症を軽減するように働きます。
食事も EoE の管理に重要な役割を果たします。最も一般的な6つのアレルゲンを取り除く構造化された除去食があります。多くの人は除去食で寛解を達成できます。また、どの食品がアレルギー反応を引き起こしているのかを特定するのにも役立ちます。
EoE 治療による症状を監視するには、医療チームと定期的に連絡することが重要です。
参考文献
- https://www.frontiersin.org/articles/10.3389/fped.2021.820192/full
- https://www.cghjournal.org/article/S1542-3565(23)00186-6/fulltext#secsectitle0040
- https://www.cghjournal.org/article/S1542-3565(23)00186-6/fulltext#tbl1
- https://patient.gastro.org/six-food-elimination-diet-sfed/
- https://www.ncbi.nlm.nih.gov/pmc/articles/PMC8721028/
- https://www.fda.gov/news-events/press-payments/fda-approves-first-treatment-eosinophilic-esophagitis-chronic-immune-disorder
- https://www.ncbi.nlm.nih.gov/pmc/articles/PMC9053490/
- https://www.cghjournal.org/article/S1542-3565(23)00186-6/fulltext
よくある質問への回答: 好酸球性食道炎の治療・関連動画
免責事項: 健康百科事典ブログは、すべての情報が事実に基づき、包括的で最新のものであるよう努めています。しかし、この記事は、資格を持つ医療専門家の知識や専門性の代替として使用されるべきではありません。薬を服用する前には、必ず医師または他の医療専門家に相談してください。ここに記載されている情報は変更される可能性があり、すべての可能な用途、指示、注意事項、警告、薬物相互作用、アレルギー反応、副作用を網羅することを意図しているわけではありません。特定の薬物または薬物の組み合わせに関する警告や情報が記載されていない場合でも、その薬物や組み合わせがすべての患者やすべての用途において安全、有効、適切であることを意味するものではありません。
